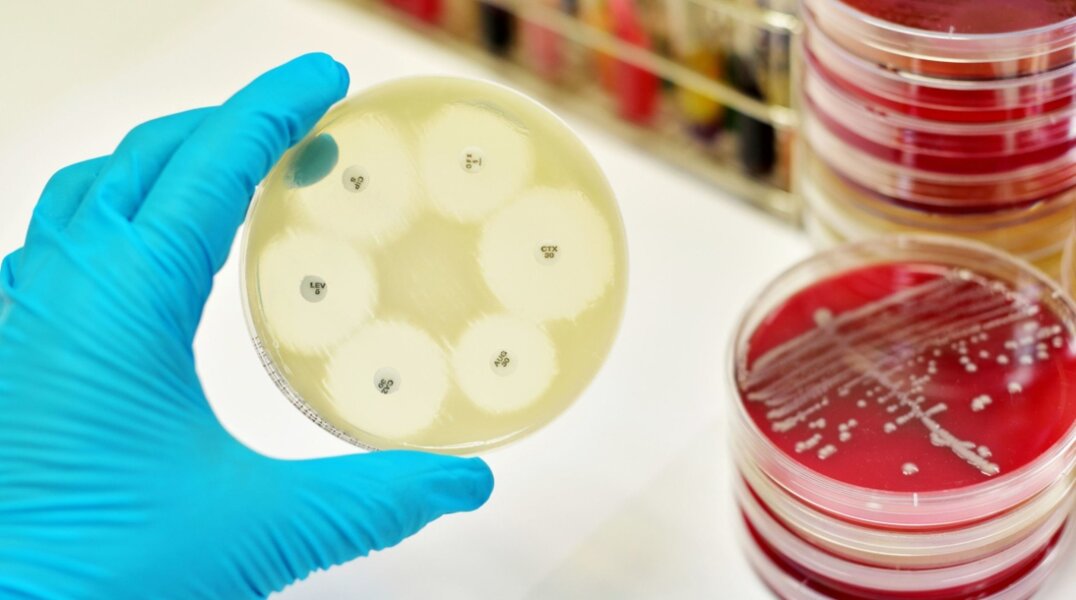
В Минздраве Прикамья рассказали, как бороться с привыканием организма к приему антибиотиков

Антибиотикорезистентность наносит вред здоровью человека.
В Министерстве здравоохранения Пермского края рассказали об опасном состоянии организма, при котором он не воспринимает действие антибиотиков. По словам специалистов, оно называется Антибиотикорезистентность и с каждым годом становится все более опасным для человечества. Из-за этой проблемы антибиотиков, которые могут эффективно бороться с бактериями, становится меньше, а риск развития инфекционных заболеваний – все больше.
Причины устойчивости организма к приему антибиотиков – в мутации вирусов и привыкании организма к этому виду лекарств. Решить эту проблему можно, если принимать курс антибиотиков только по назначению врача.
В фармакологи сегодня существует 15 групп препаратов, которые обладают антибактериальным, противогрибковым и протвиоопухолевым эффектом. Многие люди используют антибиотики не по назначению. Это может привести к тому, что организм перестанет воспринимать принимаемые препараты.
Врачи называют основной причиной Антибиотикорезистентности – привычку людей заниматься самолечением. Люди принимают антибиотики даже при обыкновенной простуде. Назначая себе такие медикаменты, они часто неправильно определяют допустимую дозировку и продолжительность курса лечения.
Иногда люди понижают дозировку лекарственного препарата и вместо двух-четырех положенных таблеток принимают только одну. В некоторых случаях заболевшие могут полностью отказаться от приема лекарств сразу после появления первых признаков улучшения самочувствия.
Специалисты отмечают, что при таком подходе концентрация препарата в крови снижается. Это может привести к выживаемости бактерий и снижению действия препарата на организм.
Также формированию устойчивости организма к препарату способствует применение антибиотиков в кормах для скота и птиц. Отмечается, что в них задействовано больше половины мирового объема антибиотиков. Препарат снижает риск возникновения у животных инфекций и улучшает их выживаемость.
Чтобы исключить устойчивость организма к действию антибиотиков, медики напоминают, что курс их приема можно проходить только по назначению медиков и выполнять все рекомендации по применению препарата. Пациентам также стоит отказаться от идеи принимать антибиотики без явной причины.
От воздействия антибиотикорезистентности на организм можно защититься, проходя вакцинацию и вовремя дезинфицируя раны.